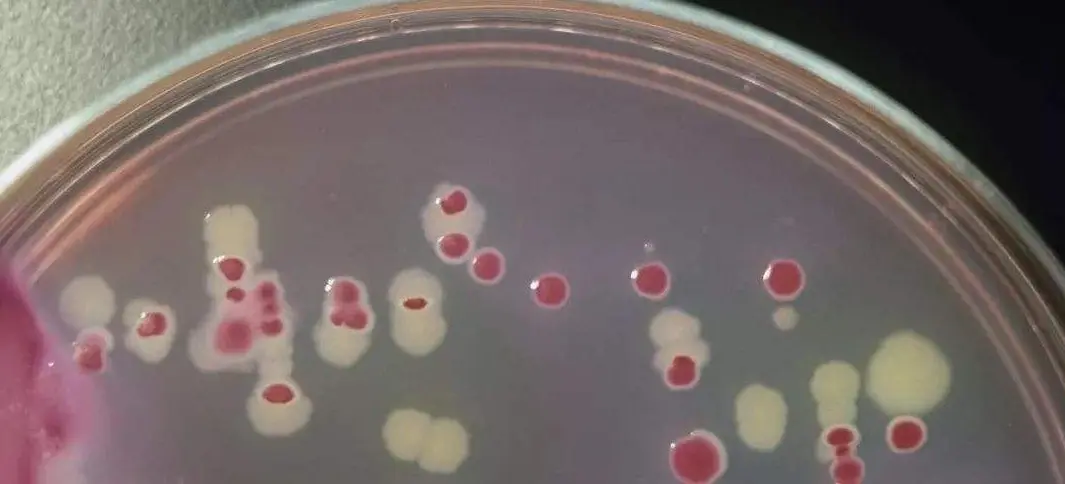
加TTC检测菌落总数
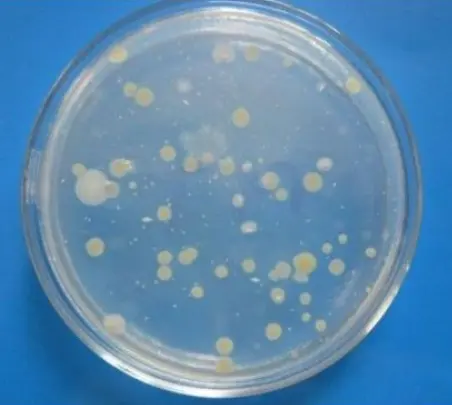
菌落计数及计算
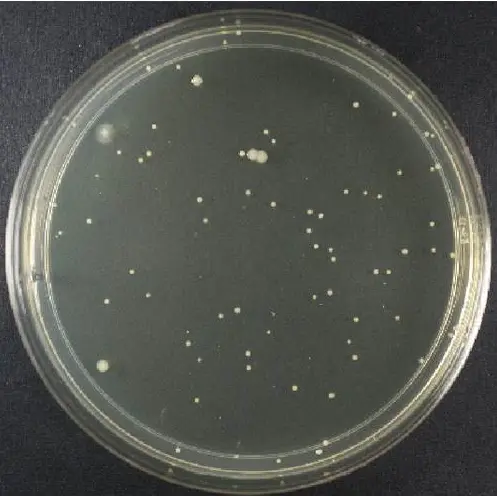
菌落计数

“菌落总数测定”标准解读,适合新手学习,老手自查!!
发布时间:2022-10-26 浏览次数:11347

一、 称样:
(1) 一般称量25g,由于称样量较大,标准中对于称样的准确性未作出明确规定,微生物室常用称样的电子天平最大允许误差为±0.1g,一般遵循“宜多不宜少”的原则,即实际称样时可根据样品情况称取超出25g (如硬质糖果等,检验人员应依据样品实际情况决定如何称样) ;
(2) 对于部分食品添加剂已明确须称取1.0g的,则须严格精确称量。
二、 样品稀释:
(1) 固体或半固体:称取25g样品于均质袋中,加入已灭菌的生理盐水225g,稍捏碎(特别是糕点/面包及其他淀粉制品),放入拍击式均质器均质 1min,此时即制备成 1:10 的样品匀液。以灭菌移液器吸取该液体至 9mL 灭菌生理盐水试管中,换上新的灭菌移液器枪头,缓缓吸取液体后反复吹打 2次,此时即制备成 1:100 的匀液,以此类推,制备10倍系列稀释匀液。
(2) 液体样品:直接吸取原液进行检验,稀释时可直接吸取1mL原液到9mL灭菌生理盐水试管中按照“固体或半固体”的方式稀释。
三、稀释度的选取:液体样品可直接取原液进行检验;固体或半固体则必须依据检验经验,选取2-3个适宜稀释度进行检验(一般样品选取1: 10, 1: 100, 1: 1000三个稀释度进行检验。若遇到不常做的样品,可适当延长稀释度至1: 100000 甚至1: 1000000)。
四、质量控制:空白对照:分别吸取1mL灭菌生理盐水到平皿中做空白对照。(若空白有菌落生长则该实验无效)。
五、平板计数琼脂(PCA):灭菌条件为121℃、15min。一般情况下于500mL敞口锥形瓶(三角瓶)中配制400mL/瓶。
六、有时样品基质比较特殊,样品匀液有细小的颗粒与菌落不易区分,此时可采用如下方法进行区分:
(1)配制1%的2,3,5-三苯基氯化四氮唑溶液(又称红四唑或红四氮唑,简称TTC),高压灭菌后避光冷藏备用。红四唑灭菌条件为:121℃、20min;
(2)待PCA琼脂培养基冷却至适宜倾注温度时,无菌加入上述TTC溶液2mL,充分摇匀(此时PCA中TTC浓度为0.005%)。
加入TTC的目的及注意事项:培养后,菌落被TTC染成红色,而样品颗粒不变色,方便计数;PCA中TTC的浓度不宜过高,否则会抑制微生物的生长,对实验结果产生影响。(特殊情况下方添加TTC,常规实验无须添加,特别是对于菌落数量较少的样品不宜添加。方法来源依据为《化妆品卫生规范》中菌落总数测定相关章节)
七、稀释液:常采用0.85%氯化钠溶液(生理盐水),121℃、15min高压灭菌后冷却备用。
八、倾注培养基时,根据对样品污染情况的估计(同一类型样品的微生物检测经验),若样品有表面蔓延生长的可能性,则待第一次倾注的琼脂凝固后,可在表面再覆盖一层琼脂以避免菌落蔓延而难以计数。
九、水产品30±1℃培养72±3h;其它样品36±1℃培养48±2h。注意:此处的“水产品”是指生鱼片、鱿鱼干等未经深度加工的水产品。
十、本标准的重难点为菌落计数及计算。
除标准中已说明的要求外,有以下几点需要注意:
(1)菌落计数时,从低稀释度的平板开始计数。若所有平板上的菌落数均小于30CFU,则须计数所有平板上的菌落数,但仅采用最接近30CFU的两个平板的菌落数来计算最终菌落总数。
以固体样品举例,菌落数选取、计算过程及结果修约如下:

(2)当第一稀释梯度一个板上菌落数高于30,另一个低于30,则依据标准应当以介于30-300之间的菌落数作为该稀释梯度的菌落数。(存在争议,实际遇到该类情况时应谨慎对待)
以固体样品举例,菌落数选取、计算过程及结果修约如下:

(3)若所有平板上的菌落数均大于30CFU,则只计数30-300CFU之间的平板上的菌落数,并采用这些数据,依据标准中给定的公式,进行最终菌落总数的计算,此时将大于300CFU的记为“多不可计”,以“TNTC”表示。
以固体样品举例,根据标准中给定的公示,菌落数选取、计算过程及结果修约如下:

(4)若所有稀释度的平板菌落数都大于300,则不能所有都计为TNTC,必须将最高稀释度的两个平板上的菌落逐一地计数,再计算平均数,该平均数为该梯度的菌落总数,其余平板上的菌落数可记为TNTC。
以固体样品举例,菌落数选取、计算过程及结果修约如下:

(5)计算菌落总数时,须严格按照标准要求进行计算。
特殊情况:
① 若所有平板均无菌落生长,则以小于1乘以最低稀释倍数。“最低稀释倍数”并不是固定不变的,与检验人员选取的稀释度有关。如:某样品多次检验后发现菌落总数较高,检验人员在梯度稀释后取1:1000、1:10000、1:100000三个梯度的稀释液倾注平板,最终所有平板上的均无菌落生长,则计算过程为<1×1000,最终结果为<1000CFU;若选取1:10、1:100、1:1000三个梯度的稀释液倾注平板,均无菌落生长,则最终结果为<10CFU。因此,稀释度的选择对于结果存在较大影响,选择时应谨慎。
② 最低稀释度两个平板只有一个平板上长了1个菌落,若为固体样品且本次检验的最低稀释倍数为1:10,此时计算过程为(1+0)/2×10=5,由于默认固体样品最小检出量为10CFU,故本次检验的菌落总数结果为10CFU。注意:对于该情况一直存在争议,不同的检验人员可能做法不一,有人保留为5CFU,有人保留为10CFU,并无固定做法。(建议检验人员保持一贯做法,不要随意更改)
举例如下:

十一、对于水产品、冷冻食品、速冻食品等菌落总数含量较高、限量值较大的食品类别,建议多增加稀释梯度(可稀释至10-4甚至10-5),避免稀释度较低、浓度较大导致培养后平板上菌落蔓延、弥散而难以计数甚至无法计数。
来源:环凯转载于食品鑫焱公众号
说明:文章、视频、图片等所有内容,仅用于学习交流,若有侵权内容及其他涉法内容,请及时联系删除或修改,特此声明!











